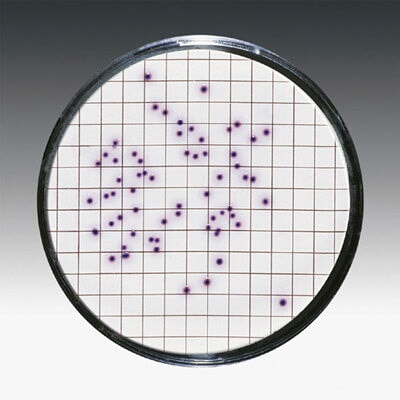
Sartorius 11406--47----ACR Gridded Sterile Cellulose Nitrate Membrane Filter, 0.45 um, 47 mm, 1000/pk

Main menu
-
- Accuris (157)
- Advantec (1543)
- Adam Equipment (561)
- Ahlstrom (811)
- A&D Weighing (680)
- Benchmark Scientific (452)
- CAS (290)
- Celltreat (698)
- DSC (120)
- Dyn-a-Med (65)
- Eagle Thermoplastics (65)
- Genie (136)
- GVS (1018)
- Heathrow Scientific (1137)
- Intelligent Weighing Technology (100)
- I.W. Tremont (644)
- Mettler Toledo (337)
- Nasco (0)
- Ohaus (2313)
- Precisa (32)
- Radwag (328)
- Ricelake (49)
- Sartorius (2415)
- Torbal (176)
- Tree (168)
- Vibra (19)
- Vistalab (273)
- Whatman (2091)
-
- Moisture Balances/Analyzers (LOD) (133)
- Spectroscopy (Optical) Moisture Analyzers (1)
- Microwave Moisture Analyzers (LOD) (9)
- Low Moisture Analyzers (LOD) for Plastics, etc... (4)
- Replacement Parts (15)
- Sample Testing & Applications Support (1)
- Sample Pads for Moisture and Fat Testers (18)
- Aluminum Dishes (43)
-
-
- Vet Scales (8)
- Wash Down Scales (80)
- Counting Scales (123)
- Pocket & Compact Scales (42)
- Bench Scales (531)
- Shipping & Floor Scales (209)
- Checkweighing Scales (49)
- Crane Scales (35)
- Health Scales (8)
- Price Computing Scales (22)
- Hanging Scales (27)
- Label Printing Scales (21)
- POS Scales (7)
- Jewelry Scales (10)
- Industrial Scales (25)
- Pill counting scales (4)
- Pharmacy Scales (10)
- Viscometers (12)
-
-
- DSC Pre-Washed and Pre-Weighed Filters (956)
- DSC Washed and Dried Filters (6)
- Syringe Filters and Syringeless Filters (852)
- Capsule Filters (299)
- Venting Filter (48)
- In-Line Filters (24)
- Vacuum Filtration (149)
- Quartz Filters (86)
- Bottletop Filter (93)
- Vacuum Protection Filters (0)
- Centrifuge Filters (204)
- Polycarbonate Filters (67)
-
- Benchkote (21)
- Weighing Papers (16)
- Seed Testing (4)
- Chromatography (38)
- Blotting Products (119)
- Lens Cleaning Tissue (3)
- Microplates (15)
- Multiwell (375)
- Printer and Accessories (47)
- Petri Dish (74)
- Pipettes and Pipette Controllers (585)
- Pipette Tips (255)
- Bottles (94)
- Micro Tubes and Caps (194)
- Flask (136)
- Containers (12)
- Beaker (32)
-
-
- Centrifuges (73)
- Centrifuge Tubes (107)
- Cryogenics (1)
- Dry Block Heaters (9)
- Evaporators (12)
- Freezer/Refrigerator (73)
- Incubators (16)
- Hotplates & Stirrers (72)
- Hydrometer (150)
- Ovens (29)
- Refractometers (45)
- SPECTROPHOTOMETER (0)
- Sterilizers & Autoclaves (14)
- Transilluminator (4)
- Thermometer (73)
- Waters Purifications Systems (18)
- Water & Oil Baths (11)
-
- Incubating Shakers Accessories (94)
- Open Air Shakers Accessories (92)
- Orbital Shakers Accessories (70)
- Vortex Mixers Accessories (70)
- Dry Block Heaters Accessories (68)
- Centrifuges Accessories (236)
- Rotators / Rockers and Incubators Accessories (40)
- Hotplates & Stirrers Accessories (8)
- LabJaws Clamps & Supports (210)
- Microscopy & Histology (77)
- Service (6)
Cellulose Nitrate Membranes
248 products
Showing 97 - 120 of 248 products
Explore our advanced nitrocellulose and mixed cellulose ester membrane filters, ideal for precise filtration needs across diverse markets. Offering a range of pore sizes, including popular 0.45 micron filters, our portfolio covers everything from cellulose acetate to nitrocellulose CN membranes.
We offer Micron-Sep, sterile and non-sterile versions of cellulose nitrate membranes, with a variety of diameters and pore sizes (from 0.1 to 12 µm). Cellulose nitrate membranes are used in many applications involving aqueous solutions, such as sample preparation, microbiological studies, and filtration of aqueous solutions. Our membranes are manufactured under strictly controlled conditions. Cellulose nitrate membranes feature very narrow pore size distribution, low levels of extractables, and increased temperature stability.